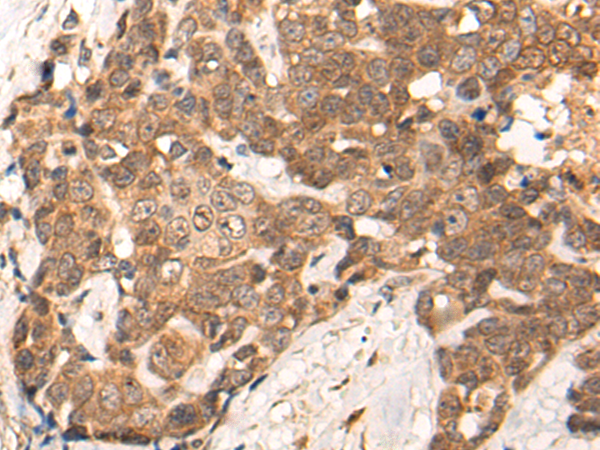

中文名稱 : 兔抗ZNF467多克隆抗體
技術規格
Background:
Transcription factor that promotes adipocyte differentiation and suppresses osteoblast differentiation in the bone marrow. Enhances the osteoclast-supporting ability of stromal cells. Binds with STAT3 the consensus sequence 5'-CTTCTGGGAAGA-3' of the acute phase response element (APRE). Transactivates several promoters including FOS, OSM and PPARG. Recruits a histone deacetylase complex (By similarity).
Applications:
ELISA, IHC
Name of antibody:
ZNF467
Immunogen:
Synthetic peptide of human ZNF467
Full name:
zinc finger protein 467
Synonyms:
EZI; Zfp467
SwissProt:
Q7Z7K2
ELISA Recommended dilution:
5000-10000
IHC positive control:
Human liver cancer and human breast cancer
IHC Recommend dilution:
25-100

購物車
購物車 幫助
幫助
 021-54845833/15800441009
021-54845833/15800441009
